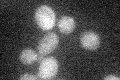
YFR010W
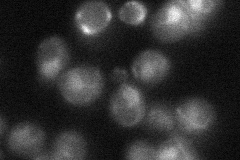
YFR010W
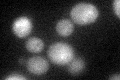
YFR010W

View description
Ubiquitin-specific protease situated in the base subcomplex of the 26S proteasome, releases free ubiquitin from branched polyubiquitin chains; works in opposition to polyubiquitin elongation activity of Hul5p
Localization:
Intensity:
Fold change:
Significance:
-
C’ GFP library in SD
cytosol19.21 -
N' NOP1pr-GFP in SD

nucleus,nucleolus151.458 -
N' TEF2pr-mCherry in SD

nucleus232.521 -
N' NATIVEpr-GFP in SD
nucleus29.5978 -
N' TEF2pr-VC and Cyto-VN in SD

#N/A0 -
C’ GFP library in SD+DTT
cytosol19.391No -
C’ GFP library in SD+H2O2

cytosol19.91.03No -
C’ GFP library in Starvation Media

cytosol16.590.86No -
C’ GFP library on the background of Pup2-DaMP

cytosol -
C’ GFP library on the background of CCT mutant

cytosolN/AN/ANo
